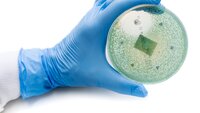
Bildet viser en hanskekledt hånd som holder en petriskål.

Innlegg av Ingrid Kvitrud som Journalist:
– Spør kronikere om sex og samliv!
Tone Granaas i Norsk Revmatikerforbund mener helsepersonell må ta ansvar.
Vil innføre obligatorisk helsekontroll med nakenhet
Frp legger i dag fram et forslag for Stortinget for å avdekke seksuelle overgrep, vold og kjønnslemlestelse mot barn. Helsesøsterleder er ikke begeistret.
Kan ha funnet våpen mot multiresistente bakterier
Norske forskere har utviklet en ny metode som kan gjøre det mulig å lage spesialtilpasset antibiotika mot multiresistente bakterier, melder NRK.
Reiser til Japan for å lære
Sykepleierstudenter og lærere skal se hvordan deres jevnbyrdige på andre siden av jorden jobber.
Lokker sykepleierstudenter med gratis kino og losji
En hel smørbrødliste med tilbud man sjelden ser i stillingsannonser skal skaffe Modum kommune bemanning til sommeren i år som i fjor.
Tid til augneblinkane
– Det ligg noko fint i å kunne sjå både elev og pasient.
Samler på blod
– Her jobber man ikke med syke mennesker.
Lærer unge om sex
– Humor og alvor må balanseres i samtalen med ungdommen.
Maler for å holde demente innendørs
Kunstner Lena Heegaard maler på dører for å forhindre at demente vandrer av gårde. Så langt har hun malt omtrent 75 dører på ulike sykehjem i Danmark.
Omgangssyken er på offensiven
Håndvask med såpe og vann fremfor alkohol, og oppvask og klesvask på 85 grader, er gode triks mot noroviruset.